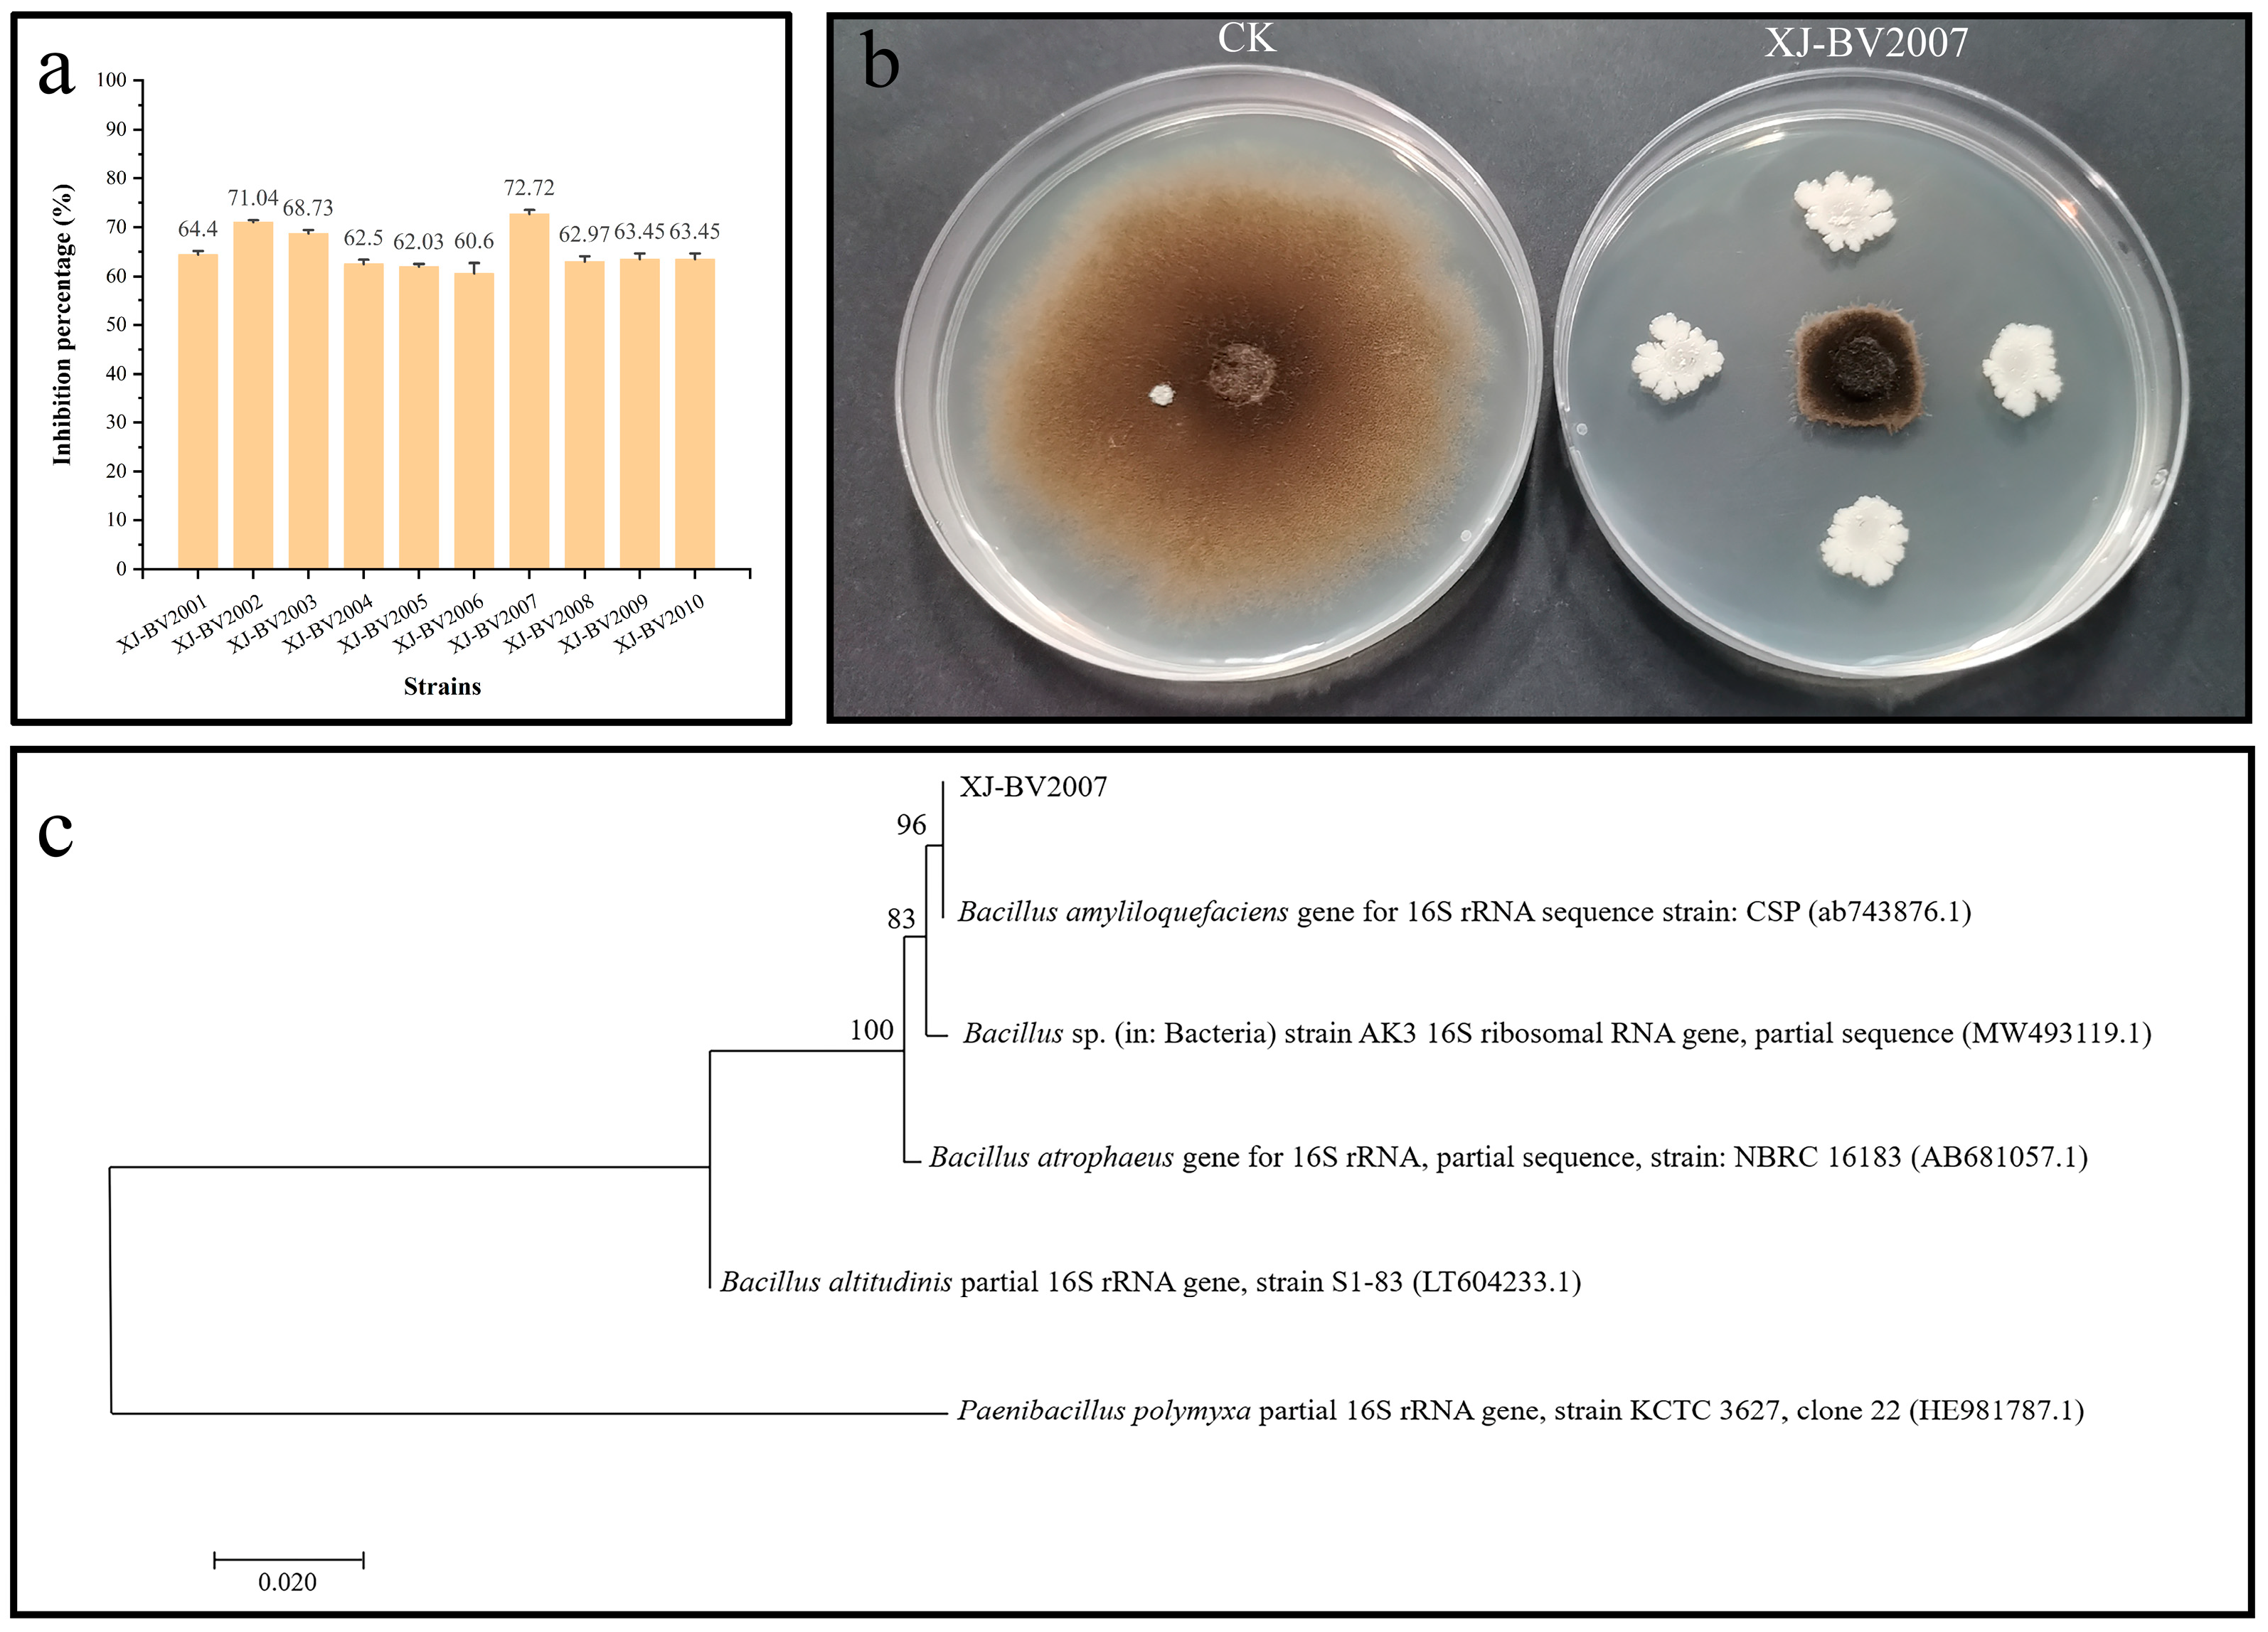

Effects of Bacillus amyloliquefaciens XJ-BV2007 on Growth of Alternaria alternata and Production of Tenuazonic Acid
Abstract
1. Introduction
2. Results and Discussion
2.1. Antagonistic Effect of Bacterial Strains against A. alternata
2.2. Molecular Characterization by 16S rRNA Gene Analysis
2.3. Co-Inoculation of Antagonistic Microorganisms and A. alternata in Tomato
2.4. Extraction, Purification, and Identification of Lipopeptides Produced by B. amyloliquefaciens XJ-BV2007
2.4.1. Antifungal Activity by Bacteria-Free Filtrate
2.4.2. PCR Amplification of Lipopeptide Biosynthetic
2.4.3. Antifungal Activity by Crude Lipopeptides
2.4.4. Purification of Lipopeptides
2.4.5. Identification of Lipopeptides Produced by B. amyloliquefaciens XJ-BV2007
3. Conclusions
4. Materials and Methods
4.1. Chemicals and Reagents
4.2. Instruments
4.3. Materials
4.4. Isolation, Screening, and Identification of B. amyloliquefaciens XJ-BV2007
4.4.1. Isolation of Strains
4.4.2. Dual Culture Bioassays
4.4.3. Detection of Alternaria Toxins
4.4.4. Molecular Characterization by 16S rRNA Gene Analysis
4.4.5. Acute Oral Toxicity Test of B. amyloliquefaciens XJ-BV2007
4.5. Co-Inoculation of Antagonistic Microorganisms and A. alternata in Tomato
4.6. Extraction, Purification, and Identification of Antifungal Compounds Produced by XJ-BV2007
4.6.1. Antifungal Activity by Bacteria-Free Filtrate
4.6.2. PCR Detection of Genes Encoding for the Lipopeptides Biosynthesis
4.6.3. Extraction of antifungal compounds
4.6.4. Purification of Antifungal Compounds
4.6.5. Identification of Antifungal Compounds Produced by B. amyloliquefaciens XJ-BV2007
4.7. Statistical Analysis
Supplementary Materials
Author Contributions
Funding
Institutional Review Board Statement
Informed Consent Statement
Data Availability Statement
Conflicts of Interest
References
- Viuda-Martos, M.; Sanchez-Zapata, E.; Sayas-Barberá, E.; Sendra, E.; Pérez-álvarez, J.A.; Fernández-López, J. Tomato and Tomato Byproducts. Human Health Benefits of Lycopene and Its Application to Meat Products: A Review. Crit. Rev. Food Sci. Nutr. 2014, 54, 1032–1049. [Google Scholar] [CrossRef]
- Liu, W.; He, X.; Fu, J.; Wu, J. Identification and toxigenic analysis of Alternaria sp. in tomato. J. Food Saf. Qual. 2021, 21, 8517–8522. [Google Scholar]
- Somma, S.; Pose, G.; Pardo, A.; Mulè, G.; Pinto, V.F.; Moretti, A.; Logrieco, A.F. AFLP variability, toxin production, and pathogenicity of Alternaria species from Argentinean tomato fruits and puree. Int. J. Food Microbiol. 2021, 145, 414–419. [Google Scholar] [CrossRef] [PubMed]
- Logrieco, A.; Moretti, A.; Solfrizzo, M. Alternaria toxins and plant diseases: An overview of origin, occurrence and risks. World Mycotoxin J. 2009, 2, 129–140. [Google Scholar] [CrossRef]
- Lemma, Z.; Dawit, W.; Negari, M.; Chaka, A.; Selvaraj, T.; Gebresenbet, G. Identification of post-harvest rotting microorganisms from tomato fruits (Solanum esculentum Mill.) in Toke Kutaye District of West Shoa Zone, Ethiopia. Acad. J. 2014, 5, 14–19. [Google Scholar] [CrossRef]
- Jiang, N.; Li, Z.; Wang, L.; Li, H.; Wang, M. Effects of ultraviolet-c treatment on growth and mycotoxin production by Alternaria strains isolated from tomato fruits. Int. J. Food Microbiol. 2019, 311, 108333. [Google Scholar] [CrossRef] [PubMed]
- Ostry, V. Alternaria mycotoxins: An overview of chemical characterization, producers, toxicity, analysis and occurrence in foodstuffs. World Mycotoxin J. 2008, 1, 175–188. [Google Scholar] [CrossRef]
- Liu, G.T.; Qian, Y.Z.; Zhang, P.; Dong, W.H.; Guo, H.T. Etiological role of Alternaria alternata in human esophageal cancer. Chin. Med. J. 1992, 105, 394–400. [Google Scholar] [PubMed]
- Bensassi, F.; Gallerne, C.; Ossama, S.E.D.; Rabeh Hajlaoui, M.; Bacha, H.; Lemaire, C. Combined effects of alternariols mixture on human colon carcinoma cells. Toxicol. Methods 2015, 25, 56–62. [Google Scholar] [CrossRef] [PubMed]
- EFSA Panel on Contaminants in the food chain (CONTAM). Scientific opinionon the risks for animal and public health related to the presence of Alternaria toxins in feed and food. EFSA J. 2011, 9, 2407. [Google Scholar] [CrossRef]
- EFSA Panel on Contaminants in the food chain (CONTAM). Dietary exposure assessment to Alternaria toxins in the European population. EFSA J. 2016, 14, 4654. [Google Scholar] [CrossRef]
- Commision Recommendation (EU) 2022/553 of 5 April 2022 on monitoring the presence of Alternaria toxins in food. Off. J. Eur. Union 2022. Available online: https://op.europa.eu/en/publication-detail/-/publication/1bd43c13-b544-11ec-b6f4-01aa75ed71a1/language-en (accessed on 21 November 2022).
- Terminiello, L.; Patriarca, A.; Pose, G.; Pinto, V.F. Occurrence of alternariol, alternariol monomethyl ether and tenuazonic acid in Argentinean tomato puree. Mycotoxin Res. 2006, 22, 236–240. [Google Scholar] [CrossRef] [PubMed]
- Noser, J.; Schneider, P.; Rother, M.; Schmutz, H. Determination of six Alternaria toxins with UPLC-MS/MS and their occurrence in tomatoes and tomato products from the Swiss market. Mycotoxin Res. 2011, 27, 265–271. [Google Scholar] [CrossRef] [PubMed]
- Zhao, K.; Shao, B.; Yang, D.; Li, F. Natural occurrence of four Alternaria mycotoxins in tomato- and citrus-based foods in China. J. Agric. Food Chem. 2015, 63, 343–348. [Google Scholar] [CrossRef]
- Shafi, J.; Tian, H.; Ji, M. Bacillus specie s as versatile weapons for plant pathogens: A review. Biotechnol. Biotechnol. Equip. 2017, 31, 446–459. [Google Scholar] [CrossRef]
- Dukare, A.S.; Paul, S.; Nambi, V.E.; Gupta, R.K.; Vishwakarma, R.K. Exploitation of microbial antagonists for the control of postharvest diseases of fruits: A review. Crit. Rev. Food Sci. Nutr. 2018, 59, 1498–1513. [Google Scholar] [CrossRef] [PubMed]
- Wu, J.; Chou, H.; Huang, J.; Deng, W. Genomic and biochemical characterization of antifungal compounds produced by Bacillus subtilis PMB102 against Alternaria brassicicola. Microbiol. Res. 2021, 251, 126815. [Google Scholar] [CrossRef]
- Rong, S.; Xua, H.; Lia, L.; Chena, R.; Gaoa, X.; Xua, Z. Antifungal activity of endophytic Bacillus safensis B21 and its potential application as a biopesticide to control rice blast. Pestic. Biochem. Physiol. 2020, 162, 69–77. [Google Scholar] [CrossRef]
- Chen, X.; Zhang, Y.; Fu, X.; Li, Y.; Wang, Q. Isolation and characterization of Bacillus amyloliquefaciens PG12 for the biological control of apple ring rot. Postharvest Biol. Technol. 2016, 115, 113–121. [Google Scholar] [CrossRef]
- Cozzolino, M.E.; Distel, J.S.; García, P.; Mascotti, M.L.; Silva, P.G. Control of postharvest fungal pathogens in pome fruits by lipopeptides from a Bacillus sp. isolate SL-6. Sci. Hortic. 2019, 261, 108957. [Google Scholar] [CrossRef]
- Calvo, H.; Marco, P.; Blanco, D.; Oria, R.; Venturini, M.E. Potential of a new strain of Bacillus amyloliquefaciens BUZ-14 as a biocontrol agent of postharvest fruit diseases. Food Microbiol. 2017, 63, 101–110. [Google Scholar] [CrossRef] [PubMed]
- Wachowska, U.; Sulyok, M.; Wiwart, M.; Suchowilska, E.; Kandler, W.; Krska, R. The application of antagonistic yeasts and bacteria: An assessment of in vivo and under field conditions pattern of Fusarium mycotoxins in winter wheat grain. Food Control 2022, 138, 109039. [Google Scholar] [CrossRef]
- Zhang, S.M.; Wang, Y.; Meng, L.; Li, J.; Zhao, X.; Cao, X.; Chen, X.; Wang, A.; Li, J. Isolation and characterization of antifungal lipopeptides produced by endophytic Bacillus amyloliquefaciens TF28. Afr. J. Microbiol. Res. 2012, 6, 1747–1755. [Google Scholar] [CrossRef]
- Cawoy, H.; Debois, D.; Franzil, L.; Pauw, E.D.; Thonart, P.; Ongena, M. Lipopeptides as main ingredients for inhibition of fungal phytopathogens by Bacillus subtilis/amyloliquefaciens. Microb. Biotechnol. 2015, 8, 281–295. [Google Scholar] [CrossRef]
- Ongena, M.; Jacques, P. Bacillus lipopeptides: Versatile weapons for plant disease biocontrol. Trends Microbiol. 2008, 16, 115–125. [Google Scholar] [CrossRef]
- Romero, D.; Vicente, A.D.; Rakotoaly, R.H.; Dufour, S.E.; Pérez-García, A. The iturin and fengycin families of lipopeptides are key factors in antagonism of Bacillus subtilis toward Podosphaera fusca. Mol. Plant-Microbe Interact. 2007, 20, 430–440. [Google Scholar] [CrossRef]
- Zhang, X.; Li, B.; Wang, Y.; Guo, Q.; Lu, X.; Li, S.; Ma, P. Lipopeptides, a novel protein, and volatile compounds contribute to the antifungal activity of the biocontrol agent Bacillus atrophaeus CAB-1. Appl. Microbiol. Biotechnol. 2013, 97, 9525–9534. [Google Scholar] [CrossRef] [PubMed]
- Guo, Y.; Huang, E.; Yang, X.; Zhang, L.; Yousef, A.E.; Zhong, J. Isolation and characterization of a Bacillus atrophaeus strain and its potential use in food preservation. Food Control 2016, 60, 511–518. [Google Scholar] [CrossRef]
- Kim, P.I.; Bai, H.; Bai, D.; Chae, H.; Chung, S.; Kim, Y.; Park, R.; Chi, Y.T. Purification and characterization of a lipopeptide produced by Bacillus thuringiensis CMB26. J. Appl. Microbiol. 2004, 97, 942–949. [Google Scholar] [CrossRef] [PubMed]
- Ravi, A.; Nandayipurath, V.V.T.; Rajan, S.; Salim, S.A.; Khalid, N.K.; Aravindakumar, C.T.; Krishnankutty, R.E. Effect of zinc oxide nanoparticle supplementation on the enhanced production of surfactin and iturin lipopeptides of endophytic Bacillus sp. Fcl1 and its ameliorated antifungal activity. Pest Manag. Sci. 2020, 77, 1035–1041. [Google Scholar] [CrossRef]
- Gikas, E.; Bazoti, F.N.; Katsimardou, M.; Anagnostopoulos, D.; Tsarbopoulos, A. Determination of colistin A and colistin B in human plasma by UPLC–ESI high resolution tandem MS: Application to a pharmacokinetic study. J. Pharm. Biomed. Anal. 2013, 83, 228–236. [Google Scholar] [CrossRef]
- Yang, H.; Li, X.; Li, X.; Yu, H.; Shen, Z. Identification of lipopeptide isoforms by MALDI-TOF-MS/MS based on the simultaneous purification of iturin, fengycin, and surfactin by RP-HPLC. Anal. Bioanal. Chem. 2015, 407, 2529–2542. [Google Scholar] [CrossRef] [PubMed]
- Zhao, H.; Shao, D.; Jiang, C.; Shi, J.; Li, Q.; Huang, Q.; Rajoka, M.S.R.; Yang, H.; Jin, M. Biological activity of lipopeptides from Bacillus. Appl. Microbiol. Biotechnol. 2017, 101, 5951–5960. [Google Scholar] [CrossRef] [PubMed]
- Guo, Q.; Dong, W.; Li, S.; Lu, X.; Wang, P.; Zhang, X.; Wang, Y.; Ma, P. Fengycin produced by Bacillus subtilis NCD-2 plays a major role in biocontrol of cotton seedling damping-off disease. Microbiol. Res. 2014, 169, 533–540. [Google Scholar] [CrossRef]
- Qin, Q.; Fan, Y.; Jia, Q.; Duan, S.; Liu, F.; Jia, B.; Wang, G.; Guo, W.; Wang, C. The Potential of Alternaria Toxins Production by A. alternata in Processing Tomatoes. Toxins 2022, 14, 827. [Google Scholar] [CrossRef] [PubMed]
- Vignesh, M.; Shankar, S.; MubarakAli, D., 3rd; Hari, B. A Novel Rhizospheric Bacterium, Bacillus Velezensis NKMV-3 as a Biocontrol Agent against Alternaria Leaf Blight in Tomato. Appl. Biochem. Biotechnol. 2022, 194, 1–17. [Google Scholar] [CrossRef]
- Ren, Y.; Yao, M.; Chang, P.; Sun, Y.; Li, R.; Meng, D.; Xia, X.; Wang, Y. Isolation and characterization of a Pseudomonas poae JSU-Y1 with patulin degradation ability and biocontrol potential against Penicillium expansum. Toxicon 2021, 195, 1–6. [Google Scholar] [CrossRef]
- Wang, C.; Fan, Y.; He, W.; Hu, D.; Wu, A.; Wu, W. Development and Application of a QuEChERS-Based Liquid Chromatography Tandem Mass Spectrometry Method to Quantitate Multi-Component Alternaria Toxins in Jujube. Toxins 2018, 10, 382. [Google Scholar] [CrossRef]
- Imade, F.; Humza, M.; Dada, O.; Ullah, S.; Jahan, I.; Eseigbe, D.; Geng, H.; Zheng, Y.; Xing, F.; Liu, Y. Isolation and characterization of novel soil bacterium, Klebsiella pneumoniae strain GS7-1 for the degradation of zearalenone in major cereals. Food Control 2023, 143, 109287. [Google Scholar] [CrossRef]
- Shang, L.; Bai, X.; Chen, C.; Liu, L.; Li, M.; Xia, X.; Wang, Y. Isolation and identification of a Bacillus megaterium strain with ochratoxin A removal ability and antifungal activity. Food Control 2019, 106, 106743. [Google Scholar] [CrossRef]
- Liu, F.; Wang, X.; Li, B.; Xun, J.; Xiao, J.; Bao, W.; Hou, X.; Zhang, X. Fertilizers and soil amendments Determination and evaluation of acute oral toxicity. In Agricultural Industry Standards of the People’s Republic of China, 1st ed.; China Agriculture Press: Peking, China, 2018; pp. 1–5. [Google Scholar]
- Estiarte, N.; Crespo-Sempere, A.; Marín, S.; Sanchis, V.; Ramos, A.J. Effect of 1-methylcyclopropene on the development of black mold disease and its potential effect on alternariol and alternariol monomethyl ether biosynthesis on tomatoes infected with Alternaria alternata. Int. J. Food Microbiol. 2016, 236, 74–82. [Google Scholar] [CrossRef]
- Shi, C. Research on Lipopeptide Antibiotics for Control of Deoxynivalenol Pollution. Ph. D. Thesis, Harbin Institute of Technology, Harbin, China, 2014. [Google Scholar]
- Hsieh, F.; Lin, T.; Meng, M.; Kao, S. Comparing methods for identifying Bacillus strains capable of producing the antifungal lipopeptide iturin A. Curr. Microbiol. 2008, 56, 1–5. [Google Scholar] [CrossRef] [PubMed]
- Chung, S.; Kong, H.; Buyer, J.; Lakshman, D.; Lydon, J.; Kim, S.; Roberts, D. Isolation and partial characterization of Bacillus subtilis ME488 for suppression of soilborne pathogens of cucumber and pepper. Appl. Microb. Cell Physiol. 2008, 80, 115–123. Available online: https://link.springer.com/article/10.1007/s00253-008-1520-4 (accessed on 1 December 2022). [CrossRef] [PubMed]
- Zouari, I.; Jlaiel, L.; Tounsi, S.; Trigui, M. Biocontrol activity of the endophytic Bacillus amyloliquefaciens strain CEIZ-11 against Pythium aphanidermatum and purification of its bioactive compounds. Biol. Control 2016, 100, 54–62. [Google Scholar] [CrossRef]

| Antibiotic | Genes | Detection in XJ-BV2007 |
|---|---|---|
| Bacillomycin D | bamC | − |
| bamD | − | |
| Iturin A | ituD | + |
| ituA | + | |
| ituC | − | |
| Surfactin | srfAC | + |
| srfAB | + | |
| Fengycin | fenB | + |
| fenC | + |
| Fractions | Inhibition | Fractions | Inhibition | Fractions | Inhibition |
|---|---|---|---|---|---|
| 1 min | − | 11 min | − | 21 min | − |
| 2 min | − | 12 min | − | 22 min | + |
| 3 min | − | 13 min | − | 23 min | + |
| 4 min | − | 14 min | + | 24 min | + |
| 5 min | − | 15 min | + | 25 min | + |
| 6 min | − | 16 min | + | 26 min | + |
| 7 min | − | 17 min | + | 27 min | + |
| 8 min | − | 18 min | + | 28 min | + |
| 9 min | − | 19 min | + | 29 min | + |
| 10 min | − | 20 min | + | 30 min | − |
| Treatment | Liquid Composition |
|---|---|
| CK | 6 mL Spore suspension of A. alternata (105 CFU/mL) + 12 mL PDB medium |
| Bacterial suspension of XJ-BV2007 | 6 mL Spore suspension of A. alternata (105 CFU/mL) + 6 mL XJ-BV2007 bacterial suspension (105 CFU/mL) + 6 mL PDB medium |
| Bacteria-free filtrate of XJ-BV2007 | 6 mL Spore suspension of A. alternata (105 CFU/mL) + 6 mL XJ-BV2007 bacteria-free filtrate + 6 mL PDB medium |
| No. | Gene | Primer Sequence (5′-3′) | Length (bp) | Lipopeptide | |
|---|---|---|---|---|---|
| 1 | SrfA [44] | F’ | AGAGCACATTGAGCGTTACAAA | 626 | Surfaction |
| R’ | CAGCATCTCGTTCAACTTTCAC | ||||
| 2 | ItuD [43] | F’ | ATG AAC AAT CTT GCC TTT TTA | 1203 | Iturin |
| R’ | TTA TTT TAA AAT CCG CAA TT | ||||
| 3 | ItuA [43] | F’ | TGCCAGACAGTATGAGGCAG | 885 | Iturin |
| R’ | CATGCCGTATCCACTGTGAC | ||||
| 4 | ItuC [46] | F’ | CCCCCTCGGTCAAGTGAATA | 594 | Iturin |
| R’ | TTGGTTAAGCCCTGATGCTC | ||||
| 5 | FenB [46] | F’ | CCTGGAGAAAGAATATACCGTACCY | 670 | Fengycin |
| R’ | GCTGGTTCAGTTKGATCACAT | ||||
| 6 | BamC [46] | R’ | AGTAAATGAACGCGCCAATC | 957 | Bacillomycin D |
| F’ | CCCTCTCCTGCCACATAGAG | ||||
| 7 | SrfAB [44] | F’ | GTTCTCGCAGTCCAGCAGAAG | 308 | Surfaction |
| R’ | GCCGAGCGTATCCGTACCGAG | ||||
| 8 | BamD [46] | F’ | GCTGGTTCAGTTKGATCACAT | 482 | Bacillomycin D |
| R’ | TTGAAYGTCAGYGCSCCTTT | ||||
| 9 | FenC [46] | F’ | CCCATCCGACYGTAGAAG | 820 | Fengycin |
| R’ | GTGTAAGCRGCAAGYAGCAC |
Disclaimer/Publisher’s Note: The statements, opinions and data contained in all publications are solely those of the individual author(s) and contributor(s) and not of MDPI and/or the editor(s). MDPI and/or the editor(s) disclaim responsibility for any injury to people or property resulting from any ideas, methods, instructions or products referred to in the content. |
© 2023 by the authors. Licensee MDPI, Basel, Switzerland. This article is an open access article distributed under the terms and conditions of the Creative Commons Attribution (CC BY) license (https://creativecommons.org/licenses/by/4.0/).
Share and Cite
Jia, Q.; Fan, Y.; Duan, S.; Qin, Q.; Ding, Y.; Yang, M.; Wang, Y.; Liu, F.; Wang, C. Effects of Bacillus amyloliquefaciens XJ-BV2007 on Growth of Alternaria alternata and Production of Tenuazonic Acid. Toxins 2023, 15, 53. https://doi.org/10.3390/toxins15010053
Jia Q, Fan Y, Duan S, Qin Q, Ding Y, Yang M, Wang Y, Liu F, Wang C. Effects of Bacillus amyloliquefaciens XJ-BV2007 on Growth of Alternaria alternata and Production of Tenuazonic Acid. Toxins. 2023; 15(1):53. https://doi.org/10.3390/toxins15010053
Chicago/Turabian StyleJia, Qinlan, Yingying Fan, Shuaishuai Duan, Qiaomei Qin, Yu Ding, Min Yang, Yan Wang, Fengjuan Liu, and Cheng Wang. 2023. "Effects of Bacillus amyloliquefaciens XJ-BV2007 on Growth of Alternaria alternata and Production of Tenuazonic Acid" Toxins 15, no. 1: 53. https://doi.org/10.3390/toxins15010053
APA StyleJia, Q., Fan, Y., Duan, S., Qin, Q., Ding, Y., Yang, M., Wang, Y., Liu, F., & Wang, C. (2023). Effects of Bacillus amyloliquefaciens XJ-BV2007 on Growth of Alternaria alternata and Production of Tenuazonic Acid. Toxins, 15(1), 53. https://doi.org/10.3390/toxins15010053

